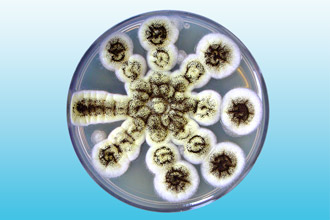
Споры гриба Аспергилус Грибковая инфекция Аспергилус

Кандидоз — наиболее распространенный микоз
Кандидоз — это грибковая инфекция, затрагивающая кожу, слизистые оболочки или внутренние органы. Она вызывается микроскопическим дрожжевым грибком рода Кандида (лат. Candida).
Грибы рода Кандида могут поражать ротовую полость, миндалины и глотку. Наиболее распространённым возбудителем кандидоза является Candida Albicans.
Этот грибок широко распространён среди людей и в небольших количествах присутствует на коже практически каждого. Чаще всего его можно обнаружить на слизистых оболочках рта, верхних дыхательных путей и половых органов. Однако наличие кандиды на слизистой не всегда приводит к развитию кандидоза.
Кандидоз ротовой полости и горла считается оппортунистической инфекцией, то есть он развивается только при ослабленной иммунной системе.
У детей, особенно до одного года, кандидоз встречается довольно часто, так как их иммунная система только начинает формировать защитные механизмы. Кандидоз у младенцев обычно не опасен и является распространённым явлением.
Ситуация с кандидозом у взрослых значительно отличается. Если у взрослого человека возникает кандидоз рта и горла, это может свидетельствовать о проблемах со здоровьем. Кандидоз у взрослых часто связан с такими состояниями, как:
- кариес;
- дисбактериоз;
- сахарный диабет;
- нарушения в работе иммунной системы.
Различные лекарственные препараты также могут способствовать развитию кандидоза.
Кандидоз горла и ротовой полости может возникнуть из-за использования кортикостероидных ингаляторов для облегчения приступов астмы. Однако чаще всего он является побочным эффектом длительного применения антибиотиков, которые нарушают естественный баланс бактерий и грибков в микрофлоре. Это приводит к снижению количества бактерий и активному размножению грибов.
Приём иммуносупрессоров значительно увеличивает риск развития кандидоза. К таким препаратам относятся противовоспалительные кремы и мази для лечения псориаза, иммунодепрессанты после трансплантации органов и другие. Кроме того, вероятность развития кандидоза, включая поражение горла, повышается при использовании гормональных противозачаточных средств.
Врачи отмечают, что грибковые заболевания в горле, такие как кандидоз, могут проявляться различными симптомами. К основным из них относятся боль и дискомфорт при глотании, белый налет на слизистой оболочке, а также зуд и жжение. Важно понимать, что эти симптомы могут быть схожи с проявлениями бактериальных инфекций, поэтому необходима точная диагностика.
Лечение грибковых инфекций обычно включает противогрибковые препараты, которые могут назначаться как в виде таблеток, так и в виде местных средств. Врачи подчеркивают, что важно не только устранить симптомы, но и выявить причину заболевания, чтобы предотвратить рецидив. Профилактика также играет ключевую роль: поддержание иммунной системы и соблюдение гигиенических норм могут значительно снизить риск развития грибковых инфекций в горле.

Типы кандидоза ротоглотки
Оральные кандидозы классифицируются на несколько категорий в зависимости от особенностей клинического проявления. Чаще всего выделяют четыре типа кандидоза ротоглотки:
- Молочница, или острый псевдомембранозный кандидоз, является наиболее распространенным грибковым заболеванием, затрагивающим ротовую полость, горло и половые органы.
Для молочницы характерно образование белого творожистого налета на слизистой рта, миндалинах и глотке. Основные жалобы пациентов включают постоянное появление налета, ощущение першения в горле, неприятный запах изо рта и снижение аппетита. Без лечения налет со временем увеличивается и становится более плотным. Температура тела и общее состояние здоровья обычно остаются в пределах нормы. Молочница часто возникает при резком снижении иммунной защиты, после курса антибиотиков и в других подобных ситуациях. В большинстве случаев заболевание успешно поддается лечению. Однако у недоношенных новорожденных и взрослых с иммунодефицитом молочница может перейти в системный кандидоз, затрагивающий внутренние органы, такие как гортань, трахея и легкие.
-
Хронический кожно-слизистый кандидоз представляет собой труднолечимое заболевание, обычно связанное с серьезными иммунными нарушениями. Для его излечения необходимо восстановление нормальной функции иммунной системы. Пациентам с хроническим кандидозом рекомендуется пройти тщательное обследование у иммунолога.
-
Эритематозный кандидоз — это специфическая форма заболевания, при которой у пациента наблюдается покраснение горла, слизистой рта и, особенно, языка. Творожистый налет в этом случае присутствует в минимальных количествах. Эта форма кандидоза может встречаться у курильщиков, людей с ВИЧ-инфекцией, а также у тех, кто принимает мощные антибиотики.
-
Хронический гиперпластический кандидоз — это форма заболевания, при которой в ротовой полости образуются лейкоплакии — ороговевшие участки, которые могут выглядеть как бляшки или пленки. Они часто располагаются в уголках рта, на языке и миндалинах. Гиперпластический кандидоз обычно связан с аутоиммунными и гормональными нарушениями в организме пациента.
| Симптом | Возможная причина (грибковое заболевание) | Лечение |
|---|---|---|
| Боль в горле, першение | Кандидоз (молочница) | Противогрибковые препараты (например, нистатин, флуконазол), полоскание горла антисептиками |
| Белый налет на миндалинах и языке | Кандидоз (молочница) | Противогрибковые препараты (например, нистатин, флуконазол), полоскание горла антисептиками |
| Красные пятна и язвы в горле | Кандидоз (молочница), другие грибковые инфекции | Противогрибковые препараты (назначение врачом), полоскание горла антисептиками |
| Сухость во рту | Кандидоз (молочница), снижение иммунитета | Противогрибковые препараты (назначение врачом), обильное питье, увлажнение слизистой |
| Трудности при глотании | Кандидоз (молочница), другие грибковые инфекции | Противогрибковые препараты (назначение врачом), обезболивающие средства |
| Изменение вкуса | Кандидоз (молочница) | Противогрибковые препараты (назначение врачом) |
| Ощущение жжения в горле | Кандидоз (молочница) | Противогрибковые препараты (назначение врачом), полоскание горла содовым раствором |
Какие еще грибковые инфекции могут поражать горло?
Не только кандидоз может поражать слизистую оболочку ротоглотки. Существует множество других грибковых инфекций, способных проникать в ткани верхних дыхательных путей. Хотя «некандидозные» грибковые инфекции встречаются редко, они представляют большую угрозу, чем кандидоз. Рассмотрим некоторые из них:
- Аспергиллез
Существует более 160 видов гриба Аспергилус, из которых 10 способны вызывать заболевания у человека. Аспергиллы широко распространены в окружающей среде — в почве, опавших листьях и гниющих растениях. Споры этих грибов легко попадают в воздух, и люди часто вдыхают их во время прогулок. Эпидемий аспергиллеза не наблюдается, что подтверждает, что микозы являются оппортунистическими заболеваниями, развивающимися преимущественно у людей с ослабленным иммунитетом. Однако случаи аспергиллеза становятся все более распространенными. В настоящее время аспергиллез занимает второе место в мире по распространенности среди грибковых инфекций (первое место занимает кандидоз).
Вдыхание спор аспергилла может привести к его прорастанию в любом из органов верхних дыхательных путей, начиная от полости рта и носовых пазух и заканчивая трахеей.
Заболевание часто путают с другими острыми респираторными заболеваниями, такими как бактериальный синусит или ларингит. Температура тела пациента может быть слегка повышенной, а выделения из носа или при откашливании имеют зеленоватый или черный цвет и неприятный запах.
- Бластомикоз
Бластомикоз — это системное грибковое заболевание, поражающее кожу и слизистую оболочку ротоглотки, а затем может затрагивать лимфатическую ткань и внутренние органы. Как и в случае с аспергиллезом, заражение происходит при вдыхании спор из почвы. Бластомикоз гортани может проявляться как в изолированной форме, так и одновременно с поражением кожи. На коже заболевание проявляется в виде красной папулезной сыпи, которая может сливаться и образовывать гнойные корки. Если на коже присутствует сыпь, диагностика становится проще. Изолированную форму бластомикоза гортани часто ошибочно принимают за другие заболевания, такие как бактериальный или вирусный ларингит, сифилис горла и т.д.
- Криптококкоз
Споры гриба Криптококкус можно найти в почве, гниющих овощах, а также в экскрементах голубей, канареек, волнистых попугаев и других птиц, реже — в фекалиях домашних животных, таких как кошки, лошади и собаки (при этом сами животные не болеют). Вдыхание этих спор может привести к криптококкозу, который поражает слизистые оболочки верхних и нижних дыхательных путей, а также органы нервной системы, включая головной и спинной мозг.
Криптококкоз — это коварная инфекция, которая может долго протекать бессимптомно. Заболевание начинает проявляться постепенно: на слизистой оболочке пораженного органа (глотки, гортани, рта и т.д.) появляются узелки, язвы и папилломы. По мере прогрессирования болезни язвы углубляются, разрушая мягкие ткани (миндалины, слизистую оболочку, мягкое небо) и даже кости. Характерной особенностью криптококкоза является то, что температура тела пациента остается в пределах нормы, независимо от тяжести заболевания. Изолированный криптококкоз слизистой оболочки хорошо поддается лечению.
Следует отметить, что криптококкоз горла редко бывает первичным; чаще он возникает в результате распространения инфекции из легких, мозга или других внутренних органов.
- Гистоплазмоз
Это системный микоз, вызываемый грибком рода Гистоплазма. Заражение происходит при вдыхании спор из почвы. В первую очередь страдают глотка, десна и небо. На слизистой оболочке образуются бугристые обширные язвы. Инфекция может распространяться в нижние дыхательные пути.
- Зигомикоз
Наиболее распространенными представителями зигомицетов являются Мукор и Ризопус. Эти грибы встречаются повсеместно — в почве и разлагающихся продуктах питания. У здоровых людей споры этих грибов могут находиться в носоглотке практически постоянно, не вызывая заболеваний. Если у человека развивается зигомикоз, ему следует пройти тест на ВИЧ-инфекцию, так как именно у людей с иммунодефицитом часто наблюдаются случаи зигомикоза. Заболевание протекает тяжело. При поражении глотки происходит разрушение мягких тканей, а затем и костей.
Грибковые заболевания горла представляют собой опасные, но редкие недуги. Они развиваются только у людей с сильно ослабленным иммунитетом.
Грибковые заболевания в горле, такие как кандидоз, вызывают у людей множество вопросов и опасений. Многие отмечают, что симптомы, такие как боль, зуд и белый налет на слизистой, могут значительно ухудшить качество жизни. Люди часто делятся опытом о том, как трудно диагностировать эти инфекции, поскольку они могут быть похожи на другие заболевания. Лечение, как правило, включает противогрибковые препараты, которые назначает врач. Однако некоторые пациенты отмечают, что важно не только принимать лекарства, но и следить за иммунной системой, так как ослабленный организм более подвержен грибковым инфекциям. Важным аспектом является также соблюдение гигиенических норм и правильное питание, что помогает предотвратить рецидивы. Обсуждая свои переживания, многие подчеркивают необходимость обращения к специалисту при первых симптомах, чтобы избежать осложнений.

Лечение грибковых заболеваний горла
На сегодняшний день фармацевтическая отрасль предлагает широкий выбор противогрибковых препаратов, включая мази, таблетки и растворы для инъекций. Мы настоятельно не рекомендуем заниматься самолечением грибковых инфекций. Успех терапии во многом зависит от правильного диагноза. Для точного определения причины заболевания необходимо пройти ряд обследований: фарингоскопию, бактериологический посев мазка из зева (для выявления типа грибка и его чувствительности к лекарственным средствам), а также общий анализ крови (для оценки состояния здоровья пациента).
Микоз горла у взрослых часто возникает на фоне ослабленного иммунитета. Важно выяснить, что именно снижает защитные силы организма, и по возможности устранить этот фактор.
Лечение грибковых инфекций горла включает в себя:
- прием системных противогрибковых препаратов (таких как Нистатин, Леворин, Амфоглюкамин, Дифлюкан);
- обработку слизистой оболочки ротоглотки местными противогрибковыми средствами (например, раствором Люголя, мазью декаминовой или амфотерициновой, полоскание 2,5% раствором буры, водным раствором пищевой соды, рассасывание таблеток нистатина или декамина карамелизованного);
- сбалансированное питание, витамины и молочнокислые продукты;
- прием иммуностимуляторов (по рекомендации врача, если лечение не приносит результатов);
- поскольку многие антимикотики могут быть токсичны для печени и крови, имеет смысл одновременно принимать препараты для их защиты.
Дозировка, частота приема и продолжительность курса зависят от возбудителя инфекции, тяжести состояния пациента и наличия сопутствующих заболеваний. Эти параметры назначаются исключительно врачом.
Вопрос-ответ

Какое лекарство лучше всего подходит для лечения грибковой инфекции горла?
Лечение молочницы полости рта. К таким противогрибковым препаратам относятся нистатин, миконазол или клотримазол. Противогрибковый препарат назначают в течение 7–14 дней. При тяжёлых инфекциях пищевода или молочнице врач может назначить флуконазол.
Что пропить от грибка горла?
Стрепсилс, таблетки для рассасывания (ментол-эвкалипт), 24 шт. Стрепсилс Экспресс, таблетки для рассасывания, 24 шт. Септолете Тотал, таблетки, 16 шт.
Как понять, что у тебя кандидоз горла?
Локализация воспалений при кандидозе полости рта: миндалины — кандидозное воспаление миндалин сопровождается покраснением, набуханием и образованием белых пятен. Боли при глотании кандидоз не вызывает. Слизистая оболочка щек — сопровождается покраснением и обильным выделением белой творожистой массы.
Советы
СОВЕТ №1
Обратите внимание на симптомы. Если вы заметили такие признаки, как боль в горле, белый налет на миндалинах или неприятный запах изо рта, не откладывайте визит к врачу. Ранняя диагностика поможет избежать осложнений.
СОВЕТ №2
Поддерживайте иммунную систему. Употребление витаминов, особенно витамина C, и сбалансированное питание помогут укрепить защитные функции организма и снизить риск развития грибковых инфекций.
СОВЕТ №3
Соблюдайте гигиену полости рта. Регулярная чистка зубов и использование антисептических ополаскивателей помогут предотвратить размножение грибков и снизить вероятность их появления в горле.
СОВЕТ №4
Следуйте рекомендациям врача по лечению. Если вам назначены противогрибковые препараты, строго придерживайтесь схемы лечения и не прекращайте прием медикаментов без консультации специалиста.